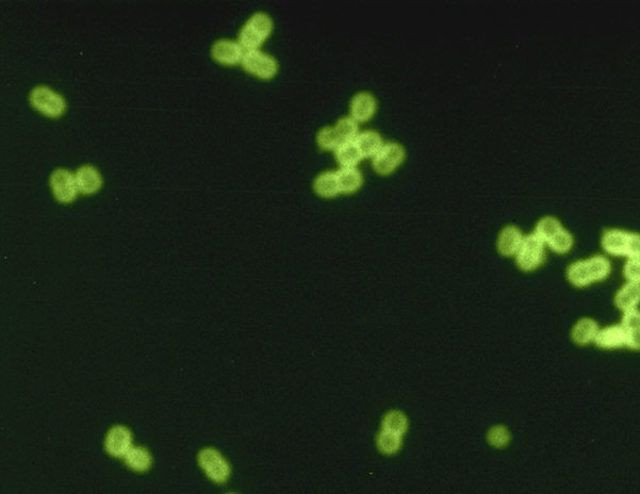
Sadece koronavirüs yok! İşte dünyadaki ölümcül virüsler - Sayfa 11

Tüm dünya, görünmez bir düşmandan korunmak için evine kapanmışken, SARS-COV-2 adıyla da bilinen yeni koronavürüs fotoğraflandı. Virüsün mikroskobik fotoğrafları ise oldukça dikkat çekici. Rochester Teknoloji Ensititüsü Fotoğraf Sanatları ve Bilimleri bölümünden biyomedikal fotoğraf iletişimi öğretmeni Michael Peres, fotoğrafların teknik sürecini anlattı.
Sadece koronavirüs yok! İşte dünyadaki ölümcül virüsler
Dünya genelinde 280 binden fazla insanın ölümüne neden olan koronavirüs, Rochester Teknoloji Ensititüsü Fotoğraf Sanatları ve Bilimleri tarafından fotoğraflandı. Fotoğrafları çeken fotoğraf iletişimi öğretmeni Michael Peres, virüsün fotoğraflanma sürecini anlatırken, diğer ölümcül virüslerin fotoğraflarını da gösterdi.


Michael Peres’in verdiği bilgilere göre, virüs fotoğraflanmadan önce bazı yollarla alınarak güvenli bir yere konuyor. Peresi Ebola, SARS, HIV gibi insanları enfekte eden virüslerin tehlikeli olduğunu ve bu virüsleri canlı ya da ölü kontrol edebilmenin oldukça önemli olduğunu söylüyor.

Elektron mikroskobuyla incelenen virüslerdeki nem uzaklaştırılır, sonrasında vakum haznesine alınan virüs elektron bombardımanına tutuluyor. Elektronlar materyalin yüzeyini yansıttığında, dedektörler tarafından yakalanır ve dedektörler virüsün görüntüsünü kaydeder. Bu sürece, monokromatik görselleştirme süreci adı veriliyor.

SARS koronavirüsü

Peres’e göre bu işlemlerde verimlilik önemli. Çünkü bu biyolojik materyallere elektron verilirken zaman kısıtlıdır, aksi takdirde virüs yok olabilir veya değişikliğe uğrayabilir. Tarama yapan bir elektron mikroskobu, virüsün dışını gösterirken, iletken elektron mikroskobu virüsün içini gösterir. Virüsün içinin görülebilmesi için bilim insanları, son derece gelişmiş ekipmanlar kullanarak, hassas bir şekilde virüsü kesiyorlar.

Belirli türde ağır metaller eklenerek, elektronların yoğunlaması sağlanır. Biyolojik materyal üzerindeki ağır ya da hafif metallar, elektronları bloke eder veya onları iletir. Böylece görüntünün beyaz ve siyah bölgeleri oluşur.Oluşan görüntü dijital teknolojilerle yakalanır. Elde edilen siyah beyaz görüntüye sanatçı müdahale ederek, görüntüyü renklendirir.

Ebola virüsü

Peres, insanların genelde bir görüntüyü renkli görmeyi beklediklerini, gri tonlarındaki görsellerin insanlarda nadir görüntü hissi yarattığını söylüyor.

1918’deki influenza salgınına yol açan virüsün tüm katmanları görülüyor

Michael Peres, bu çizim sürecini üstün teknik gerektiren bir süreç olarak tanımlıyor. Mikroskoplarda ışık yerine elektron kullanıldığı için tekniğin oldukça masraflı olduğunu söyleyen Peres, görüntünün nanoyapı ölçeğindeki çözünürlüğünü büyütmek için, görüntüyü 100.000 kata kadar büyüten Angstroms adlı süper yüksek çözünürlüklü enstrümanlar kullanıldığını belirtti. Elektron mikroskobunda elde edilen görüntünün netleşmesi için büyütülmesi gerektiğini söyleyen Peres, elde edilen görüntüyü temel alarak bir ilüstrasyon yapıldığını belirtti. Peres’e göre ilüstrasyonda kullanılan renkler ve diğer materyaller spekülatif olabilir çünkü virüsün kendi rengini gerçekten görebilen kimse yok. Buradaki ilüstrasyon sürecinin, sanatsal ilüstrasyon süreçlerinden farklı olduğunu belirten Peres, sanatsal olan ilüstrasyonlarda sanatçının işine yorum kattığını, bilimsel ilüstrasyonlarda ise virüsün gerçekten neye benzediğine dayanılarak oldukça detaylı bir çalışma yürütüldüğünü belirtti.
Streptococcus pneumoniae bakterisi. Bu bakteri menenjitin bir türüne yol açıyor.

Virüsün fotoğraflanma sürecine dair, insanların anladığı türde profesyonel bir eğitimin olmadığını söyleyen Peres, elektron mikroskopçusu veya ışık mikroskopçusu olmak için okula gitmek gerekmediğini, bu cihazların bilimde kullanıldığını, farklı kuruluşların farklı ekipmanlara sahip olabileceğini belirtti. Peres aynı zamanda öğretmenlik yaptığı Rochester Teknoloji Ensititüsü’nde fotoğrafik bilimler adında bir bölüm olduğunu ve öğrencilerin ışık ya da tarayıcı elektron mikroskoplarından birini seçebileceğini söyledi. Aynı zamanda biyoloji alanında yüksek lisans yapan öğrenciler de tarayıcı veya iletici elektron mikroskoplarına erişebiliyor. Peres, bu alanda çalışan bilim insanların herhangi bir resmi görsel eğitim almadığını, bu kişilerin esas alanının bilim olduğunu ve mikroskobun tıpkı laboratuvardaki diğer ekipmanlar gibi kullanıldığını belirtti.

VİRÜSÜN NEYE BENZEDİĞİNİ GÖRMEK BİLİM İNSANLARI İÇİN NEDEN ÖNEMLİ?
Peres, herhangi bir öğrenme sürecinde olduğu gibi, virüsü tanıma aşamasında görselleştirmenin bilim insanlarının analiz ve sonuçlandırma süreçlerine yardımcı olduğunu söylüyor. Görüntüler, mikroorganizmalar konusunda bilim adamlarına kelimelerle ifade edilen bilginin ötesinde bir bilgi sunuyor.

Bu tür görüntülerin elde edilmesi, bilimin gelişimine yardımcı oluyor. Antikor testleri veya başka tür çalışmalar, bu yolla edinilen bilgiye dayanarak gerçekleştiriliyor.